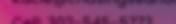

![]()

































ork from the beach to the bay e w . W We w ding dayy. W wyedour ou to design and build ork with y et us w ears. L or 15 yf vicing DE & MD y located at the beach and ser compan ent rental ents is a full-scale ev ented Ev Coastal T Tented


een. ywhere in betw erand ev



SusanLyons, publisher
susan.lyons@ coastalpoint.com
302.539.1788x102

SusanMutz, advertisingmanager susan.mutz@ coastalpoint.com
302.539.1788x107

DarinMcCann, executiveeditor darin.mccann@ coastalpoint.com
302.539.1788x103

JillianStohr, advertisingsales jillian.stohr@ coastalpoint.com
302.539.1788x106

TarynKing, editor
taryn.king@ delawareseasidebride.com
302.539.1788x108

LauraWalter, writer laura.walter@ coastalpoint.com
302.539.1788x114

ShaunM.Lambert, technicaldirector shaun.lambert@ coastalpoint.com
302.539.1788x104

CoriBurcham, writer cburcham81@gmail.com


M.PatriciaTitus, copyeditor
patricia.titus@ coastalpoint.com
302.539.1788x109

ChrisAube, designer chris.aube@ coastalpoint.com
302.539.1788x115
Itseemslikeonlyyesterdaymy youngestdaughterwasplanningher wedding.Shekeptsaying,“Mom,youneed tostartabridalpublication—it’stootime consuminglookingfordifferentvendorsin thearea.Itwouldbesomucheasiertofind everythinginoneplace!”
Itmadeperfectsense.Allofmychildren’slocalfriendsweregettingmarried,area destinationweddingsweregrowing,and coupleswhometonvacationwerecoming backtothebeachtogetmarried.Andso,ten yearsago,SeasideBridewascreated.
Venturingfromthenewspaperworld intotheglossymagazineworldhadits challengesandwemeteachofthemhead on,winningmanydesignawardsalongthe way.Wehopethatyouenjoythiseditionas wecelebrateour10thanniversaryandwish youajoyouswedding!
SusanLyons,publisher












Officiant BobMiller |Venue SeedandSaplingWeddingsandEvents| Catering TasteEvents| Cake Bride’sFather Photographer DonaJungPhotography |Flowers BayStreetBlooms |Signage CopyCentralofOceanPines Entertainment BreathofFreshAir |Hair Tiffersons |Dress CherieSustainableBridal Suit BrooksBrothers |Shoes BetseyJohnson |WeddingBands Veragio| Invitations Zola






































WordsbyLauraWalter|PhotographscourtesyHeartbeatBrandingCo.

ere’sanarttobartending,fromthetechnicalskillof pouringtothecreativityof mixing,totheefficiencyof managingacrowd.
SeanNorrisblendsitall withagenerouspourofhospitality.Heisapersonalbartenderwhoservesupagood timewithhisbusiness,Limbo Mixology.
“IlovewhatIdo.Ilovemy creativework,”hesaid,andhe wantedtotranslatethespiritedatmosphere ofagoodcocktailbartoprivateevents.“Itake people’sexperienceatthebestbarsthey’ve beento—andmakeitavailablefortheir home orwhatevervenuetheychooseand whateveramountofpeople,”Norrissaid.

colortonesforthehardware(gold,copper, stainlesssteel,rosegold).
“Ithinkitshouldkindofblendin—it shouldstillbebeautiful,”butcohesivewith theoverallevent,hesaid.

wantthathospitalitytoshow. Todothatgenuinely,Idon’t wanttobethatrobotwithatie. …Iwantpeopletofeellike they’reatapartywithfriends,” Norrissaid.
He’llchatwithguests, learntheirnames,learntheir tastesandlethispersonality shine,justasifhewasworking behindtheirfavoritebar.And yeah,ifhecanleaveanassistantinchargeforafewminutes,he’lldoalapoftheparty,checkpeople’s needsandmaybeshareajokeortwo.
Whenpeoplehostapartyatarented hallorhome(basically,anyvenuethat’snota restaurant),theyoftenneedtopurchasetheir ownalcohol,renttheglassware,storetheice andthenhirebartenderstolegallyserveitall.
“eyshouldn’thavetoworryabout that,”Norrissaid.“I’mheretotakethelegworkout.”
Heshopsforallthebooze,anyspecialty brands,mixers,glasswareanddisposables.
“ ehardestpartaboutdealingwithme shouldbejusthavingaconversationofthem tellingmewhattheywanttheirpartytolook like.…Iprettymuchdresstheentireevent.”
Clientstellhimtheparty’sthemeoraesthetic,andhedigsintothegranulardetails, fromanyspecialcocktailrecipestospecific
“Ittakesatonofforesight,problem-solving—basicallyeverythingI’velearnedtopull thatoffefficientlyandalsobecost-effective,” heexplained.“Ifyouonlywanttopayabout $200for[another]bartender,thenyou’re probablygonnadoalotmorework,butif you’relookingforthatactualexperienceor thefeelingyougetfromyourfavoritebarin D.C.orSanFrancisco,Ihaveafantasticnetwork—Ihavetwopeoplewhodoiceforme in customsizes…rentalcompaniesthatcan getwhateverIneed.…Itjustenablesmeto pulltogetherfantasticevents.”
Hiswebsiteemphasizes“tailoredbarexperiencesthatallowyoutositdownasmy guest,enjoyanintentionallycraftedcocktail (ortwo),andleaveasafriend.”
“Whenpeoplehiremycompany,Ireally
“Idon’twannabesomeonethatpeople justforget.IwantpeopletoknowI’mhereto takecareofyou.…Iwannabeabletoengage withpeople,makesuretheygetthefullexperiencetheywouldgetataregularbar,”hesaid. “If somebodyhiresme,they’rehiringmefor myphilosophy.…I’mnottheretobeaghost.” Hisphilosophyofbartendinggoesbeyondcoolequipmentorpouringskills.
“ewholepointofhospitalityistobea goodhost,”whichmeanshumaninteraction andawarenessofguestneeds,oftenbefore theyputitintowords.
“Makingagreatdrinkisfantastic,butit’s reallynotthatdifficult.You’rejustfollowinga recipe—themostimportantpartofitis makingpeoplefeellove.It’sliketheysay:a chef’ssecretingredientislove.
“Atanygiventimeinhistory,themost jubilanttimesinvolvedbooze.…Prettymuch whatIdoisaccesstocelebration.I’mamusi-
cianaswell.IverymuchviewwhatIdoasa performance,[and]thebar’sastage.It’saperformance,acelebration—youwannamake peoplefeelgreat.”
Weddingreceptions,engagementparties,specialdinners,brunchesandshowers arejustthetipoftheiceberg.Privatetastings ofwhiskey,brandyortequila,orcigarpairings,canbefunforbachelor/etteparties.Privatecocktailclassescanentertainsmall groups.Somepeopleevenenjoyprivate drinkserviceduringtheweddingweekend— fortheweddingpartywhilegettingready,ora cocktailbrunchthedayafter.
Norrisofferedthisadviceforanyonehiringabartender:askquestions.Itdoesn’thave tobeafullinterrogation,“butgettoknow whoyourbartenderis.Itcouldbeassimple as,‘I’mcurious—wherehaveyouworked?’” Askforawebsiteorsocialmedia.Askhow manyyearsofexperiencetheyhavebartendingandworkingprivateevents.
“Youwantsomeonewithexperienceto pullthatsortofthingoff,”especiallyforatrulymajorevent, likeweddings,hesaid.
Norrissaidvendors shouldbeaskingquestions,too.
“Youwantapersonthat seesthegranulardetails.Aprofessionalisgonnaseethingsthe averagepersondoesn’tthink about,”suchassunshineor shadeovertheglasses,angleof thebar,flowofguesttrafficand roomforbystanders.“Some-

bodywho’sgoodattheirjobisreallytryingto dialitin,”heconcluded.
Also,greatdrinksarenotdefinedbyalcoholcontent.Low-orzero-proofdrinksare justasartistic—perhapsevenmoreso,since theflavorscan’thidebehindthealcohol.
“Justbecausesomeone’schoosingnotto drinkdoesn’tmeantheyhaveissues.Youstill wantthemtofeelcomfortableattheevent,so Itakecaretomakesurethere’sgreatoptions forsomeonewhochoosesnottodrinkand makesurethere’sstillalotofcreativecarein thedrink,”besidesjuiceorsoda.“Youcanreallyputtogethersomefantasticconcoctions thatdon’thaveadropofliquorinthem.Itjust takessomeconsideration.”
Mocktailsarealsonicebecauseanyage orbodycansipthembutstillfeelpartofthe crowd.
LimboMixologyisbasedinLewesand cantravelacrossDelaware,Marylandandfar beyond.Foryears,Norrishonedhisskillsat variousaward-winningrestaurantsknown
fortheircocktailculture,includingFork+ FlaskinRehobothBeachandBaltimore’s MagdalenaRestaurantattheIv yHotel,and asopeningbardirectorforLewesOyster House.
Whencreatinghisownpersonalbusinessaboutfouryearsago,Norrisusedthe word“Limbo,”whichhasalwaysbeenspecial tohim.Foryears,itwaspartofhisgamertag, hisscreennameforonlineaccounts.Andbartendingislikealimbo:adanceofflexibility andfun.enthere’sthespiritualcontextof it:notquiteheavenorhell,whichhearkensto theuncertaintyofsteppingbehindabareach night.
“Ijustlikedthemystiqueofit!”hesaid. Pricewise,LimboMixologyfeesvary, “becauseatthislevel,notwoeventsarethe same.I’mliterallycreatingabaroutofnothing.”Sotheinitialconsultationiskeyfordeterminingthescopeofworkandprice.
ere’snothingwrongwithjusthiringa regularbartendertopourdrinksandhelpensureliquorcompliance—and Norriscanrecommendother peopleforthat.Buthe’sready tohelphostscreateamore charismatic,detail-orientedexperience.

B esidesspecialevents, Norrisalsoconsults,helping peopledesigncocktail programsfortheirhomebars. Learnmoreat LimboMixology.com.


Weddingguests.Possiblythewedding partyandorcouple,dependingontime.
Atimeforgueststomingle,chat,and enjoylightrefreshmentsandentertainment beforethereceptionevent.
Postceremony,pre-reception.Typically lastsanhour(asthenamesuggests).
Usuallyinaspaceseparatefromthe ceremonyandreception.iscanbeanoutdoorgardenpatio,apooldeck,ahotel rooftop,beachareas,etc.
Somecouplesusethistimetokeeptheir guestsentertainedwhile thephotographer takesalltheweddingportraitsofthecouple andtheirweddingparty.Othersusethistime totransitionfromtheformalenergyofthe ceremonyintothemoreactiveandexciting atmosphereofthereception.
Fromphotoboothsandcornholeto champagnetowersandlivemusic,thisisa spacetogetcreativeandsetthevibeforthe restoftheevent.Bringontheappetizersand signaturedrinks,butmakeitmemorable.










Crispwhites,icypastels,andcandyshadesare theidealspringpalette.Foranearlycoastal wedding,pullsoftshadesofblueandembracefloraltoilepatterns.Ifweatherallows, optoutsideforthatfresh,springairanddelicatenaturalbloomstoenhanceyourceremonydreams.
PhotographybyStacyHartPhotography
Bringonthecolor!Goforvibrantjeweltones andgardenvibeswithbrassygold,andrattan fortexture.Don’tbeafraidtomixandmatch. Wowyourguestswithahanginggardenfloralinstallationovertablesorthedancefloor, andbringinunexpectedelementslikeacold brewmartinibar!
PhotographybyHeatherBakerPhotography
Earthtonelovers,thisisyourseason!We’re bringingbacktheterracotta,rusts,andgolds. Addsomeunexpectedsparklewithdisco ballsdoneright.Don’tlettherainstopyour photoop!Clearumbrellas,twinklelights,and raindropsareamatchmadeinheaven.
PhotographybyLeahAdkinsPhotography
Aclassicblackandwhitepalettewilltakeyou farinthechillymonths.Loaduponwhiteflorals,candles,greenery,andpopsofgold.Keep yourguestscomfortablewithcozylounge areasdrapedinsoftblanketsandlooktostylishmobilebarstoservewarmbeverageslike spikedhotchocolate,ciders,andmore!
PhotographybyChelseaFluhartyPhotography
Delmarva’scoastalclimateensuresthatnomatter theseason,it’stheperfectlocationtotietheknot.













WordsbyGraceBennett,Intern PhotographybyMariaDeforrestPhotography, MoGarrattPhotography
Here’sachancetodiscoverthetopweddingmakeuptrendsof2026sofar,blending softglamwithpersonalflair!Highlighting looksthathavegotbridescompletely hooked,herearesomeexperttipsfromAshleyCatlett,ownerofBellissimaSkinLLCand EasternShorePermanentMakeup.
eprimarytrendthathaswonover thebridesthisyearleanstowardsoft,romanticglam,withbridesrequestingalookthatis
authenticyetmakesthemfeelbeautifulandconfidentontheirwedding day.
“Manybrideswanttolooklike themselves,favoringnaturalstylesover heavytransformations,”saidCatlett.
Fromdewylookstonaturalneutraltones,akeyfocusthisyearhas beenpinkandlighttonesforeyeshadowsandlips,whichcreatesatimeless








September28 th 2024






CeremonyLocation AllSaints’EpiscopalChurch |Venue eClubhouseatBaywood| WeddingPlanner MakeMyDayEvents Cake CarolinaSugarFairy |Photographer AlexSchonPhotography| Flowers eClubhouseatBaywood,FloralInspirations Hair JessicaLee,StudioTwentiTwo |Dress/Suits TreasuresFormals&Bridal,BellaCouture,Jos.A.Bank Invitations/Signage ePaperyofPhiladelphia| Rings HarryKAtlanticJewelry| Transportation FirstClassRollsRoyce
lookthatisversatileacrossallskintones. Dewyfinishescontinuetobeapopularrequestamongbrides,asitgivesahealthy,naturallooking,glowingcomplexion.
“Bridesareoptingforlighterapplicationstoletfeatureslikefrecklesshine through,”Catlettsaid.
atpreferenceforminimalcoverage, unlessfullconcealmentisneededforimperfections,allowsbridestoreflecttheirpersonalstylewhilestillglowingontheirbig day.
Eyemakeupisevolving, withsofter techniques.
“Shadoweyelinersarereplacingsharp liquidliners,forasofter,romanticvibe,” Catlettsaid.“isshift,pairedwiththeresurgenceofbrownlinerandmascara,adds warmthandenhancesthegentle,glowing aestheticbridesareembracing.”
Personalizationisattheheartof2026’s bridalmakeuptrends.Catlettsaidbridesuse makeuptoexpress theiruniquestyle,butshe

cautionedagainstunrealisticexpectations.
“epicturesofInstagrammodelsthey wanttouseforinspirationarenotgoingto lookthesameonthem.Mostofthosepicturesarefilteredoreditedand,especially,eye looksarebasedontheeyeshapeandcolor,” saidCatlett.
Sheemphasizedhowimportantitisfor bridestocommunicatetheirvisionclearly, whilebeingopentoadjustmentsthatarebetterfitfortheirfeatures,associalmediaimagesofteninvolveheavyediting.




Skinpreparationisanotherkeyfactorto keepinmindforthatflawless,glowylook.
“Agreatskincareroutineisthebackboneofperfectmakeup,”saidCatlett.
Sheurgesbridestostartworkingwitha trustedestheticianmonthsinadvanceto boostskintextureandradiance,tonotonly havehealthy,clearskinforthebigdaybutto promotelong-termskinhealthaswell.
Forbrideslookingtoembracethese trends,bookingamakeuptrialcanbekeyto testingalookthatcomplementstheirfeaturesandweddingstyle.Whetherthey choosethedewylookortheirownradiant mix,theperfectwedding-daylookcanbe achievedbystartingaskincareroutineearly, sharingrealisticinspirationphotos,andselectingalookthataccentuatesone’snatural beauty.
ese2026trends—emphasizingradiant,perfectlytailoredlooks—alongside Catlett’sexpertadvice,willhelpguarantee thatthebridecanradiateconfidenceonher bigday.

























Yousaidyes—arguablythemostimportantpartofkickingoffaweddingplan.But nowyou’vegottogoaboutplanningthe thing.Somesaythispartisthemostfun,outsideofsaying‘IDo’,ofcourse!Butyou’restartingwithacompletelyblankslate,andunless you’vebeenplanningyourweddingday longerthanyou’vebeenanadult,youmight evenbealittlelostastowheretostart.You mightenlistthehelpoffamilyandfriends, scourPinterest,andstartyourideaboards. You canalsoturntotheprofessionals.Seaside Bridechattedwiththreeofthearea’smost sought-afterweddingandeventplanners aboutupcomingtrendsfor2026,theirfavoritepartoftheplanningprocess,andthe visualmoodboardstheycreatedforyourinspiration!
HappyHourEvents: DanaFerreri,Owner&Planner www.happyhoureventsde.com
Q
Whatisyourfavoritepartoftheevent planningprocess?
A“Workingwiththeclients,Igetallmy energyfromtheirhappinessandappreciation,andIreallydobecomeattachedto theminaway.Attheendofitall,there’soften agenuinefeelingofdevelopedfriendshipon bothends,justfrombeingincontactwith eachothersomuchandsooften.”
Q
Whatdoesthatinitialdeepdiveinto yourclient’spre-planningweddingvisionlooklike?
A“Typically,Ischeduleaface-to-face meetingorZoomcalltogooverthe couple’sbudget,talkaboutideastheyhave, andsharesamplephotosfrompinboards, etc. It’sallaboutcustomizingwhattheclient wants!Ifocusonwhatresonates,whatmakes sense,andthenwhatcanactuallyworktogether.”
Q
Areyouseeinganyupcomingtrends thatyou’reexcitedabout?
A“Caterpillartables!Ilovethewaythey windaroundandthroughthereception space—butyoureallyneedalotofspaceto makeithappen.”
Dana’sMoodBoardInspo: Jewel Tones,Non-traditionalInteractive,& Dramatic
TasteEvents: KatieGreen,DirectorofEvents www.tasteeventsandcatering.com
Q
Whatisyourfavoritepartoftheevent planningprocess?
A
“Ilovethatinitialprocessandgoingback andforthwiththeclientandhelping themfindtheirvision.Recreatingcertain thingsfromtheirlives—forinstance,acustombarfromtheBahamas—learningabout thecouple,takingtheirinspirationandbringingitintoreality.”
Q
Whatdoesthatinitialdeepdiveinto yourclient’spre-planningweddingvisionlooklike?
A
“Aftertheinitialconversationdiscussing budgetandanybigideas/wants,clients oftenprovideaPinterestboardorinspiration photos.Weworktogethertoguidethemand helpnarrowthingstoalevelofcohesion—
especiallywithcolorsandfloral,and thenlinensandotherdecorations.”
Q
Areyouseeinganyupcoming trendsthatyou’reexcitedabout?
A
Weekdayweddingsarebig.Couplesaregoingforsofterfabrics— cottonsoverpoly.Colorpalettesinolive green,slateblue,mint(lovemint),beige, andsand.Also,white-on-whiteand bringinginbudvasesforpopsofcolor.
Katie’sMoodBoardInspo: Sustainability,Botanical,Custom&Classic
ASweetAffairEvents: KatinaDawson,Owner&Planner www.asweetaffairevents.com
Q
Whatisyourfavoritepartofthe eventplanningprocess?
A
“ecouples!Everyweddingandevent isdifferent,soreallyunderstandingthe dynamicsofeachcoupleandtheirplanning teamisimportant.Seeingthecoupleand







































































































Q
Whatdoesthatinitialdeepdive intoyourclient’spre-planning weddingvisionlooklike?

































Ahowtheyworktogether—Ienjoymeeting withbothpartiesandtrulygettingtoknow themastwoindividualswho’vecometogether.Weallspendsomuchtimetogether,I sometimesfeelavoidonceit’sover.”

“Iwanttoseeanyvisualinspiration youmightalreadyhave,evenifit doesn’tseemcohesivetoyou.Alotof times,whenaclientispullingouttheir inspiration,thefloristandIwillseethe commonalitiesinvariouspicturesthat theclientisn’tevenawareexist.Wecan pointthoseoutandhelpyoupullitall togetherintoacompleteidea.”
Q
Areyouseeinganyupcoming trendsthatyou’reexcitedabout?
AColor.Lovecolor!We’veseenitfor abitnow,andit’sdefinitelycontinuing.I’malsohappythatwe’renotseeingsomanygarter/bouquettosses.Ihaven’t hadaclientinterestedineitherofthoseina while.
Katina’sMoodBoardInspo: Bright, Organic,Colorful,&Floral



May17 th 2025









CeremonyLocation&Venue CampArrowhead| WeddingPlanner HappyHourEvents
Catering RetroStreetEats| Photographer StacyHartPhotography |ContentCreator MaidofContent
Flowers DaughterFloral |Entertainment DJPhilatPowerPlayEntertainment |Hair/Makeup UpdosforIDos Dress AnthropologieWeddings |Rentals CoastalTentedEvents+PrettyLittleWeddingCo




“Grace,green,andgardensweretheinspirationforthis elegantbutnaturalthemedbridalshootatBrittinghamFarms, alavenderweddingvenuetuckedjustbeyondtheDelaware shoreline.Gardengreensgracedthetablesettings,andaflowy bridalgowncomplimentedthesurroundingfarmland,while thebrightlavenderfieldsandthesettingsunservedasan elegant,butorganicbackdrop.”
–MoGarratt




VendorList:
•Planner/Model: JennyHowat, OpalAvenueEvents
•Venue: LauraBrittingham, BrittinghamFarms
•Florist: OliviaYoder,FarmGirlFloralsllc.
•Photographer: MoGarratt, MoGarrattPhotography
•Rentals: JimHess, VisionFurnitureEventRentals
•Cake: JenniferLow, eFrostedFoxCakeShop
•Dress/Suit: eDressMatters BridalBoutique
•Signage: CaitlynCarter, DowntoEarthDesigns
•Stationary: ViaSketchStudio
























WordsbyTarynKing|PhotographscourtesyCrystalFinneganPhotography

Tetheredtheirentirelivesthroughmutualfriends andvaryinglocations,SeanandAlyssacameface-tofaceforthefirsttimeintheearlydaysofhighschool in2011.Despitetheirattractiontoeachother,timing eludedthemthroughoutschool,keepingthemineach other’sorbitbutneversingleatthesametime.Duringa rareDelawaresnowstorm,theybothjoinedagroupof mutualfriendstogosledding.“Iabsolutelyhatethe cold,soIwasmiserableformostofit,butafterwardswe wenttoSean’shouseandhungoutintheirgameroom. ThisiswhereSeankissedmeforthefirsttime.Istill feelthosesamebutterfliesafter10yearstogether.”
Ashigh-schoolseniorsinnorthernDelaware,theybondedoveraloveofsunsets,baseball,andBoston,MA—”Ironically,FenwayParkhasthemostbeautifulsunsets.Wetalked abouthowonedaywewouldbuyacondothatoverlookedFenwayParkandwatchthesunsetsandbaseballgamestogether.”AlyssasaysthiswasthemomentsherealizedshehadafuturewithSean.
In2017,theyboughttheirfirstfur-babytogether,America,andluggedherbackandforth betweentheirparents’homesfor4yearsbeforedecidingtobuytheirfirsthometogetherin 2021.Atthatpoint,theyaddedanotherdogtotheirlittlefamilyandnamedhimBoston.
CarouselPark,inWilmington,becameafavoritehauntforAlyssaandSean,especiallyas abackdropfortaking“familyphotos”withtheirdogs.InOctoberof2022,Seanproposedduringoneoftheirparkvisits.
Originally,thecoupleconsideredholdingtheirweddinginsouthernPennsylvania,dueto affordability,butthenchosetoputtheirweddingplansonholdforvariousreasons.Inpicking thembackupagain,Seansaid,“Itwouldmakesenseforustogetmarriedattheplacethat holdssomuchspaceinourhearts…weshouldlookdownstate.”Asavidbeachloverswho spendmostsummerweekendsdownatthebeach,thisplanquicklyfellintoplace.
AlyssaandSeanhadfriendswhoweremarriedatWillowbrookinBridgeville,andthe photosofthemainbuilding’sblackexteriorandmultipleoutdoorceremonylocationscaught theireye,sotheydecidedtosetupatour.eWillowbrookWoods(oneof6ceremonyoptions)waserectedaftertheirfriend’sweddingandwastheexactaestheticthatAlyssawanted fortheirday.“WhenSeanandItouredWillowbrook,wewalkedbackintothewoodsandsaw theceremonywall—Iwasabletoenvisionallofourlovedonesgatheredhere.Iwasableto picturethebrightflorals,andIwashitwithsomuchemotion;Icouldalreadyfeelthelove. Tearsimmediatelyfilledmyeyes,andIknewthatthiswastheplacewhereIwasgoingto marrymybestfriendandtheloveofmylife.”iswasthefirstandonlyvenuethatthecouple touredinDelaware,andtheyimmediatelyendedtheirsearch.
May30th,2025,AlyssaandSeansaidtheir‘IDos’andofficiallytiedtheknot.Euphoric, timeless,andintentionalarethethreewordsthecoupleusedtodescribetheirweddingday. Withapastelpaletteandfairytalevibes,thedaywasnothingshortofmagical.Everycouple




strivestomaketheirdayunique andmemorable,andforAlyssa andSean,thesentimentaltouchesincorporated throughouttheday,notjustforthemselvesand thebridalparty,butfortheirguestsaswell,are whatstoodout.Somefunexamplesincludea tableofweddingphotosofalloftheirmarried guestswithasignthatread“TooseWho WalkedBeforeUs”,hand-writtennotes,andpink begoniasgiftedtothebridesmaids,thecouple’s weddingvowsincustommadenotebooks—”We willusethesenotebooksthroughoutourlivesin placeofgreetingcards.Foreverybirthday,holiday,anniversary,specialoccasion,orjustbecause,wewillwritethethingswewanttosayto eachotherinournotebooks.”AndSeaside Bride’sfavoritedetail:thebride’sseconddress wornduringthereception;thebottomhalfcame fromhermother’sweddingdress,andthetop halfcamefromtheMotheroftheGroom’sweddingdress.Alyssasaid,“Iwantedtohonorher [MotheroftheGroom]inthesamewaythatI honoredmyownMom,soIcameupwiththe ideaofincorporatingbothoftheirdressesinto one.iswassuchafunprojectthatIwasableto putsomuchcreativityandloveinto.”
Officiant: JohnMeredith
CeremonyLocation: WillowbrookWoods
Venue: Willowbrook
DayofCoordinator: LainaElizabethEvents
Catering: SkylineCatering
Dessert: SweetMelissa’s
Photographer: CrystalFinneganPhotography
Flowers: Styled
Signage: Styled/Self/Etsy
Entertainment: DJHype
Hair: 1MakeupMan
Makeup: 1MakeupMan
Dress/Suits: MaggieSottero/MeshkiLysandreCrepe/FormalAffairs
Shoes: Lulus-Kimo
Engagementring:JanvierJewelers
Weddingbands: Holden/StagheadDesigns
Invitations: EmilyStrycharz
Accommodations: TruByHilton



ecouple’svenuechoice didnotdisappoint.Fromtheir walk-throughtothedayafter,theyhadseamless communicationwithKarenandKatelyn,the ownerandoneofthevenue’steamleaders,respectively.“OurexperienceworkingwithWillowbrookwasincredible. 10outof10.Nonotes. IfIhadanyquestionsorconcerns,Iwasableto sendatextmessageoranemail,andtheywould getbacktomewithin24hourswithananswer.” EveryideathecouplehadtheWillowbrookteam answeredwithan“absolutelywecandothat”. “SeanandItrulyfeltlikewewerethemostimportantpeopleintheworldtotheWillowbrook Staff.eywentaboveandbeyondeverything wecouldhaveexpected.”
Inadditiontotheirindoorandoutdoorceremonylocations,Willowbrookalsoprovidesa BridalSuiteandGroomRoomforthedayof,to relaxandgetready.Someadditionaldecorative elementsareavailableforuse,includingantique doors,floralrings,andboxwoodwalls.
evenuedoeshavesomerestrictions,i.e., noconfetti/streamers,noopenflames,no sparklerexits,noshotsfromthebar,andalistof
pleaseturntopage27


















September7 th 2024








CeremonyLocation&Venue RehobothBeachCountryClub| WeddingPlanner AlexandraNesterakEvents
Photographer KimberlyF.DennPhotography |Videographer BEVideography |Flowers RitualFloralStudio Hair/Makeup FineArtBeauty |Dress MoniqueLhuillier| Rentals WhiteGloveRentals/BBJLinens
EngagementRing Boone| Invitations LiketheBird| Tents EasternShoreTentsandEvents
preferredfoodandbeveragecateringvendors. Dogsareallowedduringtheceremonyandfor pictureswithpre-approval.emainhall’sbuildingcapacityis250people,andthepropertyis fullyaccessibleforguestswithspecialneeds,featuringwheelchair-accessiblebathroomsandeasy accesstoallareas,includingtheuseofgolf-carts foranygueststhatmayhavedifficultygetting intothewoodsontheirown.
FormoreWillowbrookdetails,photos,and contactinformation,pleasevisittheirwebsiteat willowbrookweddingsde.com/Recommended bookingis6-12monthsinadvance.
Whenaskedwhatadvicetheymightoffer tocouples,AlyssaandSeanhadtwosuggestions:
1.)“Dowhatfeelsrightforyouandyour partner.eonlywayyoucandoweddingplanningwrongisifitisn’twhatyoutrulywant.Just becausesomethingis“traditional”doesnotmean thatyouhavetoincorporateitintoyourwedding.Youareinchargeofwhatyourwedding daylookslike,andifatraditiondoesn’tresonate
withyou,youdon’thavetodoit!”
2.)“Yourvendorsarethemostimportant partofyourweddingday.Iwouldliketosaythat wehadtheabsoluteBESTcurationofwedding vendorsinourarea,anditshowedineverysingle detailofourwedding…Makesuretoreadreviewsanddon’tbeafraidtokindlydeclineservicesifyouarenotvibingwithavendorduring yourintroductions.”
Whathaslifebeenlikeforthecouplein theseearlymonthsafterthewedding?Alyssa said,“Ourtimehasbeenblissfullyspentatthe DelawareBeaches.Wedecidedtopushourhoneymoonoutuntilafterthesummerbecausewe didn’twanttomissoutonallthatourfavorite placehastooffer.Whyspendthemoneytogoto abeachdestinationwhenwehavetheperfect beachesrightinourownbackyard?Luckilyfor us,lifehasbeenjustaboutthesameasbeforethe wedding.Spendingtimewithourfriendsand family,andreallyjustenjoyingeachother’scompany.eonlythingthat’sreallychangedhas beenmylastname.”


























































WordsbyDarinJ.McCann|PhotographscourtesyNDPPhotography,JeffBergen/GettyImages&Sara+Ryan/GettyImages
Aneternalloop.
Foryears,thegoldweddingbandhas servedasasymboloftheendlessandcontinuousbondoflovebetweentwopeoplewhohave openlypledgedtheircommitmenttooneanotherforperpetuity.Itisbothadeclarative statementtotheoutsideworldthattheindividualis“taken”byanother,andapledgeofloyalty, loveanddevotionbetweenindividuals.Itiseasilyidentifiable,oftenelegantinitssimplicity, andoneofthefewiconicelementsoftradition thathasstoodthetestoftime.
Anditcanbeagiantpaininthebutt. Itcatchesonthings.Itgetsimbeddedin thefleshwhentheravagesofsummerhitdueto waterretention.Itisjewelry—and,quite frankly,alotofpeoplejustaren’twildabout wearingjewelry.
Butfearnot.ereisreliefoutthere,men. Or,whoever.Ifagoldweddingbandisnot somethingthatgrabsyourinterest,butyoustill cravethatsymbolismoftheendlesspathoflove
betweentwomarriedpeople,thereareoptions. Let’sgettothem.
No,we’renotsuggestingyouandyourintendedget“Taken”tattooedonyourforeheads. But,ifthat’syourthing…hey,youdoyou.isis ajudgement-freezone.
Butifyou’relookingforapermanentsymbolofyourlove,thereisverylittlewecanoffer youtodaythatwilloutliveatattoo.eyaren’t goingtofalloffinthesurf.eyaren’tgoingtobe stolen.Youwon’thavetogetthemre-fitted,or taketheminforcleaningandmaintenanceevery year.ey’reoftencheaperthanbandsfeaturing rareorpreciousmetals.Plus,ifyou’relookingfor theopportunitytocreateaone-of-a-kindsymbol ofyourlove,whatbetteropportunityisthere thantheclearslatethatisyourownflesh?
Aretheresomenegatives?Well,youcan’t justripitoffandflingitintotheoceanifyouget divorced,atleastwithoutmakingabitofamess
ofyourhand.Fingertattoosdohurt,andthey tendtofadealittlefasteronourhands,thanksto washing,sunexposureandthinnerskin.Inaddition,there’sstillsomeofthesocietalstigma thingywithtattoosinsomecornersoftheworld in2025,meaningjobopportunitiescouldbelimitedbyvisibletattoos.
Hey,somepeoplejustdon’twanttoweara ring—beitbecausetheirprofessionmakesitdifficultortheysimplydon’tlikethefeelingofwearingthem.Or,justmaybe,theyliketheideaofa weddingbraceletornecklaceinstead.Freecountryandall,right?
Andtherearesomedistinctadvantagesto alternativeaccoutrementsoverthetraditional ring ereismorespaceforengraving,simply becausethere’smorerealestateavailablethanon aring.And,inthatvein,thereismoreofanopportunitytopersonalizeitandmakeitstandout

inawayyouandyourpartnerwoulddesire.Or, maybe,youjustwanttodosomethingthat’snot necessarilythesametraditionalthingpeople havebeendoingforgenerations.
ereareamilliondifferentreasonsyou mightpreferabraceletornecklacetoaring,includingsensitiveskin,anactivelifestylethat makesitdangeroustoweararingorsimplyadesiretostandoutwithyourownlook.It’syour wedding.It’syourmarriage.It’syourlife.Make thedecisionthatisbestforyou.
Takeallofthosereasonswejustgavefor braceletsandnecklacesinlieuofatraditional weddingband,andaddtheadditionalbenefit

ofbeingabletotell timewithit—andthereyouhavetheargumentforbespokewatches.
Obviously,therearemore,startingwith thepreferencesoftheindividualwhowillbe wearingthejewelry.Inaddition,thereisa monetaryvaluehere,asthewatchdoublesas atimepieceandafashionaccessory,providingsomebangforthebuck.
Ontheflipside,batteriesdieandmechanicalworkingssometimesstop,well, working.Sothere’sprobablyalittlemore maintenanceinvolvedthanyougetwith aring.

So,maybeyoudolovethetraditionofthe weddingband,butyouwantsomethingthatis lesslikelytogetdamagedthanthegoldorother traditionalmetaloptions.inksilicone. AccordingtoeGentleman’sSmith,there areatonofadvantagestogoingwithsilicone,including comfortandflexibility,affordabilityand durability,andthey’rehypoallergenic,whichcan comeinhandyifyougetreactionstometals.
Ontheflipside,theylistnegativesasadifficultyinre-sizingifthatcomesup,andlimited designoptions,andtheydon’tgetviewedas beingasformalastraditionalweddingbands. Again,yourchoice.Youdoyou.

September28 th 2024








CeremonyLocation BethanyBeach,DE |Venue BaysideResortGolfClub| Flowers/Signage Styled.| Invitations TrulyEngaging Dessert MillStreamFarmBakeStudio| Photographer ArborLaneStudios| Entertainment DarlingWeddingProductions Hair Tiffersons |Makeup BeautybyJacs |Dress/Suit SandalsBridal,HugoBoss| WeddingBands ParkPlaceJewelers

DaniWinterswasafarmgirlwholeft hometoexploretheworld,claimedherpart init,andthencamebackhometogrow. Today,sheistheownerofWintersFarmFlorals,afull-servicefloralbusinessthathonors traditionandinnovation.
Dani’sfatherisafirst-generationfarmer andoneoftheearliestno-tillfarmersonthe easternshoreofMaryland."Asafirst-generationfarmer,it'stakenalifetimetobuilduphis farmtowhatitistoday.Hestartedfromabsolutescratch,buildingfromthegroundup." ForDani,thiswasabittersweetexperience. Growinguponthefarm,shelovednature, playinginthefieldsandnearbywoods,and watchingherdadputhisallintotheland.Her rootsrundeep,butshewasn’tsureshe wantedthatlifeforherself.Danigotthewanderbuganddecidedtoleavehometofinish hereducationandtravel.Sheindeedtraveled theworldandthenworkedineducationfor7 yearsafterfinishingcollege.Butsometime aroundtheage of30,Danihitawall,feeling unfulfilledinthelifeshehadbuiltforherself.
After12yearsaway,Danicamehometo theEasternShoreandstartedworkingforher dadonthefarm.isgavehertimetolearn alltheinsandoutsofagricultureandseeif therewereanyfacetsofthefieldshewanted topursue.In2019,Danidecidedtostartalittleflowergardenonthebackofthefarm.She
wantedtoputtouse alltheknowledgeand sustainablepractices she’dlearnedfromher dad.
eflowershad juststartedtocomein whenCOVIDhit.Danifeltlike,throughall thepainandanxiety,theworldneededmore flowers.eflowershadabitofagoldenage duringthattimewithsales,andherbusiness startedtoflourish.In2021,sherealizedthat this‘little’businesswasbiggerthanshewas. “eflowersweretakingeverything—7days aweek,andIhadtomakeadecision.Itwas timetopivot,andIdecidedtobringthe flowerfarmtomyhomeinSalisbury.”Atthe endofthe2021season,thefirstgreenhouse wentinwithanewonegoingupeveryyear.
“Iwantedtofocusongettinggoodat growingflowersforthefirst3years,and focusonbuildingoutthewholesalebusiness. Alotoffloristsdidn'thavemanyfarmpartnersatthetime,andsoIcameinatareally beautifultimeandmadesomewonderful connections.Itcanbesortofcutthroat,so youreallyhavetohaveyourgrowingprocess downpat”explainsDani.Sustainabilityplays alargepartinthatprocess.“Weimplement sustainabilitywherewecan,weusealow-till system—onceeverytwoyears—forthe


flowerfarm.elesswecandisturbthenaturalgrowingenvironments,thebetter.We’re alsomovingawayfromtheinsecticideprogramandherbicidesandtryingtobeanosprayfarm.We’removingtotarpingand lettingMotherNaturekillthoseweeds!”
Neveronetobalkatachallenge,Dani kickedofftheweddingsideofthebusiness withherownweddingin2023.Shegrewall theflowersherselfandthenhandedeverythingofftoanotherdesignerwhodidan amazingjob."eweddingfloralscame aboutorganically.Iwasaskedtodotheflowersforafriend'swedding,thenanother,andit trickledinto2024.Itwassortofunexpected."
Dani'spassionliesingrowingflowers, andsoalargepartofthebusinessliesinprovidingflowersforwholesale.However, throughsellingtoandworkingwithotherdesigners,Danialsolearnedaboutthemechanics,colorpalettes,tips,andtricksoffloral design.Danilaughs,"Callitpassivetraining,if youwill.Ihavetalenteddesignersallaround mewhoI'vebeenprivilegedtolearnfrom.I


stillbringinfreelancedesignerstohelpduringthebusyseason."Puttingherhandtodesignhasledtosomeamazingcompositions andarrangements,andarecentlystyledshoot onfamilyhuntingpropertyontheWicomico River.eshootfeaturedWintersFarmfloralsinadesignstyleshecalls"EasternShore meetsCoastal".
Today,thefloralfarmoffersthreepackages:full-serviceweddingflorals,seasonalà lacarte(aflexiblemediumbetweenfullserviceandDIY),and DIYfarm-pickup.While mostofthefloralsonofferaregrownonthe

farm,Danicanorderothers."Weddings comewithalotofvision,andweliveinaPinterestworld.Wedon’twanttolimitpossibilitiesforourbridesandgrooms,andsome flowerslikerosesorhydrangeasareflowers wegrow,butifit’soutofseason,thenwewill ordertheminandsupplementwithourown.”
Formoreinformation,visitwww.wintersfarmflorals.comandtaketheirquizto learnwhichpackageistherightfitforyour weddingfloralneeds.








WordsbyAvaLindia-PointInternPhotosby BrittanyLauren
Inthemodernera,asingledresshashad tofitthecriteriaforanentireweddingday. eclassybridehadtocompromisecomfort forstyleinasculptedbodiceandcathedrallengthtrain,whilethebridewholovedto danceworriedhowhersingulardresswould accommodatesweatandlegmovement.
It’ssafetosaytheweddingworldis changing,andsoaretheoutfits.Inrecent years,therehasbeenagrowingshifttoward wedding-day“secondlooks,”orreceptionoutfitchanges.Ithasbecomeespeciallypopular amongstbrides,butgroomsarestartingto catchontothetrendaswell.
eoriginofthetrendisdifficulttopinpoint,butcelebritieshavebeenwearingsecondlookssincetheearly2000s.Chrissy Teigenisknownforherthree-partchangeat her2013wedding,whileHillaryDuff’sswitch fromshoulderpadstoatwo-piecesetmade wavesin2019,andthenthere’sMeghan Markle’sshiftfromasilkgowntoahigh-neck StellaMcCartneydressin2018.
Butwhosaysthetrendisjustforcelebrities? Oursocialmediafeedsarebooming withthesecond-lookweddingtrend.
Manybridescite comfortorfashionas thereasonfortheir weddingoutfitshift, while,forothers…it’s dramaticeffect.Some bridesarguethatthey areunabletoexpress themselveswhollywithjustonewedding dress.Somesaytheyaren’tabletotakepart (comfortably)inalltheweddingtraditions thatmakethedaysospecial,suchasdancing, inasingledress.
In fact,there’sastrongupwardtrendof couplesbreakingtraditionalexpectations, andthereisnohard-and-fastrulethatsaysa bridecanonlywearonedressonherweddingday!
Sowhatexactlyarebrideschanging into?Two-piecesets,free-flowingmini dressesandwide-legjumpsuitsaregaining popularityduetotheirabilitytoaccommodatemovementandoffercomfortforbrides duringreceptionfestivities.Besides,wedding daysareversatile—outfitsshouldbenoless


so! Bridesaregenerallykeepingtheirceremonylooksformalbutmakingreceptionoutfitsfun,andeventurningfinalsend-offssexy.
MariaMcEvoy,ownerofSandalsBridal &FormalWearinOceanCity,Md.,offered someinsightintothetrend.Sheisquitefamiliarwiththepractice,asshe’switnessedmany bridesinrecentyearshopingtofindmore thanoneperfectdresswhileshoppingatSandals.
Forbrideslookingtotakepartinthe trend,McEvoyoffersafewbitsofadvice:“I advisemybridestofindadressthatoffersdetachablesleeves,strapsandskirts,”shesaid. “Somebrideswantaballgownandamore form-fittinggownfortheceremony.Inthis case,theywouldneedtwodresses.”
Forbrideswantingtodoasecondlook
butwhowanttoavoidtheprocess(andexpenditure)ofaseparateoutfit,McEvoysuggeststheypurchaseafitteddress andaddafulloverskirttogive anenhancedballgownlook.
“erearemany waystogetsecond looksoutofoneweddingdress,”shesaid. “etrendnowis detachablesleeves, strapsandskirts, whichgivesthelook oftwodressesfora fractionofthecost.”
Whatlooksare becomingincreasingly popularatSandals?
McEvoysaidcomfort hasbecomeapriorityfor manybrides.

wearingagiantT-shirt.”
isbridalexpert’stakeontherising trend,andthequestionofwhether secondlooksarenecessary:“It’s allaboutpreference.Tome, ifyouloveadressandit bringsyoutotears,why purchaseasecond dress?Butthatisonly myopinion.”

“Bridesarelookingforlighter dressesand/ordressesmadeofjerseymaterial,whichmakesthemfeelliketheyare
Whetherthey wanttokeepitsimpleandsavvyinone beautifulballgown, orinsteaddetach sleevesandskirtand headtothedancefloor, bridesaretakingcharge oftheirwedding-daylooks nowmorethanever.Trendor tradition—yourspecialdayis aboutyou,andyourweddinglookshould be,too.

Sheddingthemoreinfamous aspectsofitsreputation, elopementisnolonger viewedasariskyfinalresort forcouplesseparatedby circumstance.Theimageof runawayloversfleeing togetherinsecrethas becomemorefictionthan reality,and,nowadays, elopementhasgrowninto apermissiblealternative totheconventional, full-scalewedding.



Giventhecelebration’slonglistoftraditions,expensesandloftyexpectations,many couplesareoptingforamoresimplifiedelopementormicro-weddingthatprioritizesthe mostessentialpart:eachother.CouplesplanningadestinationweddingtotheDelmarva coastwillfindabreadthofvendorsthatcan notonlyaccommodateamoreexclusiveguest list,butthathaveanexpertiseinservices suitedtointimate,small-scaleweddings.


DespitetheirassociationwithLasVegas chapelsorcity-hallclericalnuptials,elopementsaren’tthatdifferentfromthemoreexgantcelebrations,withtheonekey differencebeingscale.Insteadofresortingto sweepingballroomsforapartyofsix,thereare plentyofvenuestoexplorealongtheDelaware coastthatcanhostsmalleventswithoutcompromisingontheromanticcoastalaesthetic.
Withaviewofbuoyingboatsonthehorizonandthetideslappingagainstthepier,the InnatCanalSquarecanbetheidealvenuefor thosewhofavoranauticalaestheticwithout sinkingtheirbudget.
NestledalongtheLewesHarbor,the Nantucket-stylehotelhasanaffordablepackageforspecialoccasionsthatcanserveupto 55guestsfordinner—aperfectfitformicro-



weddings.eSpinnakerPackageincludesthe useoftheirWaterviewRoomfortheceremony,theParkviewRoomforthereception, andaccesstothecanalandharborviewing deckthroughouttheevening.
Sincebothweddingpackagesatthis venuefeaturethesameceremonyroom,every newlywedcouple,nomatterthesizeoftheir guestlist—canenjoythesameromanticambience,butsmallerpartiesbenefitfromaless extravagantrate.
AtHopkin’sHeartlandinLewes,theexpanseoffarmlandsandtheclassicwooden barnsattheCoveredBridgeInncombine modernelegancewitharusticfarmhouse charm—especiallyinitssmallestvenue, HoneyBee.espace,whichcanaccommodateupto85people,hasapergolafortheceremony,anuncoveredandcoveredpatioforthe reception,andeightfarmhouse-styletablesset upfordinnerwithinarefurbished,sage-green barn.eruralsetting,pairedwiththedistant accompanimentofcricketsandbirdsong,can lendtheweddingafairytalevibewithoutgivingawaythekingdom.
Formoreinformationonthesevenues, visitwww.theinnatcanalsquare.comor www.hopkinsheartland.com.
edecisiontohostamicro-weddingor elopementcanbeginwiththehumblewishto spendthatspecialdaywiththosetowhomthe coupleareclosest.Giventhattheexclusive guestlistfeaturesonlyaselectfewfriendsand familywhohaveaspecialconnectionwiththe
brideorgroom,it’sessentialtohireawedding photographerwhocancapturesuchanintimategatheringonfilm.
JesandChris,thehusband-and-wifeteam behindHand&ArrowPhotography,specializeinelopementsandpreservingthebigday forcouplesgettingmarriedonDelmarva.
Inadditiontothestandardwedding-day moments—fromthefirstlooktothefirstkiss —Hand&Arrow’sphotographycapturesthe essenceoftheromanceandadventureoften associatedwithtraditionalelopement. roughatmosphericcandids,theirteamcan expertlypreserveboththemagicofthecouple’srelationshipandtheirchosennatural venue—optionsthatarediversethroughout Delmarva.
Whetherthecoupleisgettingmarriedon apublicbeach,ataninnbythebay,orabarn backingwoodlands,Hand&Arrow’sphotographyservices—whichstartat$5,000forfulldaycoverageoflocalweddings—can encapsulatethepassionthatfirstinspiredthe couplenottowaitthetraditionallengthof timetobeunited.
FormoreinformationaboutHandand Arrow’slocalelopementpackages,visit www.handandarrow.com.
Insteadofsomethingborrowedandblue, couplescanstartanewweddingtradition withsomethingliterallyshortandsweet. Elopementsandmicro-weddingsnaturally favorminimalismovergrandiosedisplays.And withitstoweringlayersofdecadentwhite
frostingandatendencytowardsexcess,one traditionthatoftengetsdownsizedorreplaced entirelybyanothersweettreatisthewedding cake.
However,atSweetDisposition,asmall businessandlocalbakerybasedinSelbyville, Del.,coupleshavetheoptionofdesigningtheir ownminiweddingcakethat’stheidealserving sizeforsmallergatherings.Partnerscan chooseapredesignedcakefromthebakery’s DessertShopalbumorcancustomizethecake tofittheirwedding’stheme.
Toscheduleaconsultation,call(302) 436-3616.
Forcoupleswhowanttoeliminatethe hassleofweddingplanningaltogether,BarefootBrideWeddings—aweddingservice thatcuratesready-madebeachweddingson thesandyshoresofOceanCity,Md.—offers cost-effectivepackagessuitedtosimpletastes. eElopement&VowRenewalpackage,whichservesthecoupleandfourguests atthepriceof$899,includesabeachceremony,anon-denominationalofficiant,photographer,basicdécorandtheoptiontoadd on areceptionattheCoastal59venue.
Inthespiritoftheevent,BarefootBride Weddingsprovidesthehappycouplewith enoughplanningsupportfortheweddingto retainthesamespontaneousfeelingofelopementsbutwiththeefficiencyofapartyyearsin-the-making.
Formoreinformation,visitwww.barefootbeachbridesoc.com.

August12 th 2024








Ceremony/VenueLocation AshoreResort&BeachClub |WeddingPlanner LisaWilgus| Dessert ShoreBakedCo. Photographer DonaJungPhotography/LaurenHowardPhotography |Flowers AprilCutter
Entertainment EncoreEntertainment |Hair KatherineBenton |Dress/Suits Pronovias/J-Crew EngagementRing Sophia’sFineJewelry |WeddingBands BrilliantEarth,ManlyBands
Yourguidetolocalresources Formoredetaileddescriptionsofservices,visitDelawareSeasideBride.com
HockersFamily
Restaurant&CrabHouse
30244CedarNeckRoad OceanView,DE19970
302.537.8900
BeachHouseDewey
1710CoastalHighway
DeweyBeach,DE19971
302.227.4000
BeachHouseDewey.com
•Modernoasisinheartof DeweyBeachwithoutdoorpool
•Oceanside,nearthe
RehobothBeachboardwalk
•FreeWiFi,microwaves,refrigerators andflat-screenTV
DowntownBridal
301TilghmanRoad,Ste107
Salisbury,MD21804
410.543.5332
DowntownBridals.com
•Dressesforwomenofall shapesandsizes
•Bridalgowns,bridesmaids’dresses, flowergirldresses,mother-ofthe-bridedressesandgroomattire
•Alterationsonsite
SandalsBridal &FormalWear
9927StephenDecaturHwy.
OceanCity,MD21842
410.390.3937
410.390.5160
OceanCityMDBridal.com
•Bridal,bridesmaids,mother’s, prom&cocktailsavailable inallsizes
•Men’sformaltuxedos&suits forrentorpurchase
•Weddingpartiesof6ormore, thegroomisFREE
•LGBTQfriendly
•VIPappointmentsavailable uponrequest
SomethingComfortable
122RehobothAve
RehobothBeach,DE19971
302.227.6180
Something-Comfortable.com customerservice@somethingcomfy.net
•BeautifulDesignerLingerie
•Delmarva’scertifiedBraFitterin
RehobothBeach,offersyouthe verybest
RenaissanceMedSpa
atPeninsulaPlasticSurgery
314WCarrollStreet, Salisbury,MD21801
410.546.0464 and 30265CommerceDrive, Millsboro,DE19966
302.663.0119
PenPlasticSurgery.com
•Nationallyaccreditedon-site surgerycenter
•Non-invasivebodycontouring, lasertreatmentsandinjectibles
•Facials,microderms,waxingand moreinourmedspa
hockersrestaurant@yahoo.com
FollowusonFBandInstagram!
•Privateroomforupto40
•Large,openvenuespacefor upto350
•Customizedmenusby awardwinningchef
TasteEvents
Adivisionof CommonGroundsHospitality
410.615.2560
TasteEventsandCatering.com
•Choosefromoneofourfour restaurantlocationsor anyoff-sitelocation
•Customcateringpackages foreventsofanysize
•Barservicesavailable
ChesapeakeBartenders andEvents
ServingDE,MD,VA&DC
443.276.9911
ChesapeakeBartenders.com
Full-servicewedding,bar andcateringexperiences
• 5-starratedandtrustedby theregion’stopvenues
• TIPS-certifiedstaffwithfull liquorliabilitycoverage
• Signaturecocktails,curatedmenus andluxurywoodenbar+bar designrentals
GreaterGoodEventsby Children’sBeachHouse
1800BayAvenue Lewes,DE 302.645.9184
GreaterGoodEventsDE.com
•On-andoff-sitecatering
•Bay-frontvenuewithindoor andbeachsideoptions
•Aportionofcostsbenefit Children’sBeachHouseprograms
ASweetAffairEvents
410.913.1738
ASweetAffairEvents.com
•Awardwinningfullservice weddings&events
•Designservices
•Specializinginbeachweddings
BaysideResortGolfClub
12021NorthHavenDrive Selbyville,DE19975
302.436.3400
GolfBayside.com
•JackNicklaus SignatureGolfCourse
•#1GolfcourseinDEfor14 straightyears-GolfweekMagazine
BaywoodGreens
32267ClubhouseWay LongNeck,DE19966
302.947.9800
BaywoodGreens.com
•18-holechampionshipgolfcourse
•MostscenicgolfonDelmarva
•Fantasticcourseforanyonefrom beginnertopro
BearTrapDunesGolfClub
7ClubHouseDrive
OceanView,DE19970
302.537.5600
BearTrapDunes.com
•27-holestrategicmasterpiece
•3milesfromBethanyBeach,DE
•Top5CourseinDEby GolfweekMagazine
DowntownBridal
301TilghmanRoad,Ste107
Salisbury,MD21804
410.543.5332
DowntownBridals.com
•Dressesforwomenofall shapesandsizes
•Bridalgowns,bridesmaids’dresses, flowergirldresses,mother-ofthe-bridedressesandgroomattire
•Alterationsonsite
SandalsBridal &FormalWear
9927StephenDecaturHwy. OceanCity,MD21842
410.390.3937
410.390.5160
OceanCityMDBridal.com
•Bridal,bridesmaids,mother’s, prom&cocktailsavailable inallsizes
•Men’sformaltuxedos&suits forrentorpurchase
•Weddingpartiesof6ormore, thegroomisFREE
•LGBTQfriendly
•VIPappointmentsavailable uponrequest
OceanViewJewelers
35785AtlanticAvenue OceanView,DE19970
302.537.1121
OVJewelers.com
•Customdesign
•Jewelryrepair
•Wideselectionofengagement &anniversaryrings
•Askusaboutourbridalpackage
ReverandRomas
A.Laskauskas
ServingDE,MD&PA
203.733.0168
Rlaskauskas1@verizon.net
•NonDenominational WeddingOfficiant
•AmericanMinistriesCertified
•LGBTQ+Friendly
•MultilingualCeremoniesAvailable
AshleeEmerson
Photography
hello@ashleeemersonphotography.com (302)285-9842
AshleeEmersonPhotography.com
•Delaware+Destination Photographer
•Preservingyourcherished momentsw/artistry&finesse
ShannonRitter
Photography
shannonritterphotography@gmail.com
ShannonRitterPhotography.com
ServingCouplesinDelaware, Virginia,Maryland,&Pennsylvania
•Delaware-basedwedding &familyphotographer
•Weddings,proposals, engagementsand familyphotographer
CleanDelaware
33852ClayRoad
Lewes,DE19958
302.684.4221
CleanDelaware.com
•Luxuryrestroomtrailers
•Eventpackages&kids’ restroomsavailable
•ServingKentandSussexCounty
CoastalTentedEvents
35283AtlanticAvenue Millville,DE19967
302.539.5211
TentedEventsDe.com
•Tentsforbeachand large-scaleevents
•China,linens,chairs, portablerestrooms&more
•Lighting&décoraccessories
ServingDelmarva
443.528.3397
PartyPoopersDelmarva.com
• 2,4&5Stationluxury restroomtrailers
• StringentSanitationProtocols
• Hassle-freerentalexperience
ClubhouseatBaywood
32267ClubhouseWay LongNeck,DE19966
302.947.9225
BaywoodClubhouse.com
•AwardWinningGardens&CeremonyGrounds
•OpenYear-RoundtothePublic
•StunningViews&CoastalCuisine
CoastalKitchenat
BearTrapDunes
7ClubhouseDrive OceanView,DE19970
302.537.5600
BearTrapDunes.com
•Award-winningchef
•Delectabletwistson classicpubfare
•Expansivedrinkselection
•Indoorandoutdoorseating withgreatvistas
GrainontheRocks
43CapeHenlopenDr Lewes,DE19958
302.291.3900
GrainOnTheRocks.com
•Waterfrontrestaurantandbarwith outdoorseatingandlivemusic.
•LocatedattheCapeMay-Lewes FerryTerminal
•Tentedweddingreceptionson theDelawareBay,accommodating morethan300
HockersFamily Restaurant&Crabhouse
30244CedarNeckRoad OceanView,DE19970
302.537.8900
hockersrestaurant@yahoo.com
FollowusonFBandInstagram!
•Privateroomforupto40
•Freshseafood,handcutsteaks, steamedcrabs&more!
•Customizedmenusbyaward winningchef
Hooked
8003CoastalHighway OceanCity,MD21842 410.723.4665
HookedOC.com
•Award-winningchef’scuisine
•Fullcateringservices throughTasteEvents
•Weddings,events, rehearsaldinners
OfftheHook
769GarfieldParkway BethanyBeach,DE19930 302.829.1424
OffTheHookBethany.com
•Openallyear,lunchanddinner
•Localseafoodandproduce
•Off-sitecateringthrough TasteEvents
SignaturesatBayside
12021NorthHavenDrive Selbyville,DE19975
302.436.3200
SignaturesAtBayside.com
•Beautifulgolfcourseviews, uniquetothebeach
•Charmandcomfortof homemadeSouthernfavorites infusedwithcontemporary, coastalcuisine
Tailchasers
12203CoastalHighway OceanCity,MD21842 443.664.7075
TailchasersOC.com
•Waterfrontdockbar
•Outdoordining
•Privateareaforrehearsals &receptions
WheelhouseBar&Grill
7AnglersRd Lewes,DE19958 302.291.2163
WheelhouseDe.com
•WaterfrontDiningon theLewesCanal
•IndoororOutdoorDining
•Privatediningroom
•Weddings-EngagementsHolidayParties-FundraisersBaby/BridalShowersBusinesMeetingsRehearsalDinners
CleanDelaware
33852ClayRoad Lewes,DE19958
302.684.4221
CleanDelaware.com
•Luxuryrestroomtrailers
•Eventpackages&kids’ restroomsavailable
•ServingKent&SussexCounty
JungleJimsPetCare
1705CoastalHighway DeweyBeach,DE 302.988.4186
JungleJimsTotalPetCare.com
•DoggieDayCarebythebeach!
•OvernightandGroomingServices
•WeddingPackages&More
PartyPoopersInc
ServingDelmarva
443.528.3397
PartyPoopersDelmarva.com
• 2,4&5Stationluxury restroomtrailers
• StringentSanitationProtocols
• Hassle-freerentalexperience
SandalsBridal &FormalWear
9927StephenDecaturHwy.
OceanCity,MD21842
410.390.3937
410.390.5160
OceanCityMDBridal.com
•Bridal,bridesmaids,mother’s, prom&cocktailsavailable inallsizes
•Men’sformaltuxedos&suits forrentorpurchase
•Weddingpartiesof6ormore, thegroomisFREE
•LGBTQfriendly
•VIPappointmentsavailable uponrequest
Airplanes& AdventuresTravel
AshleySwope,traveladvisor 814.659.1014
Agents.TravelLeaders.com/ Ashley_Swope ashleyswope@aatravel.com.co
•SpecializinginHoneymoons, DestinationWeddings,Group &FamilyTravel
•Customconcierge-levelservice
BethanyTravel
DreamVacations,Inc. 28436DuPontBoulevard Millsboro,DE19966
302.933.0955
BethanyTravel.net
•Destinationweddings
•Customizedplanning
•Honeymoons
ChasingSeahorses
Workingwithclientsallovertheglobe
302.545.5772
info@chasingseahorses.com
ChasingSeahorses.com
•Professionalteamwith first-handexperience
•RomanticGetaways, DestinationWeddings
•Addedperks&amenities
BearTrapDunes
GolfClub
7ClubhouseDrive OceanView,DE19970
302.537.5600
BearTrapDunes.com
•Grandclubhouse surroundedbygorgeous groundsandviews
•Award-winningchef
•Perfectforindoorand outdoorcelebrations
CapeHenlopenStatePark
15099CapeHenlopenDrive Lewes,DE19958
302.644.5005
DeStateParks.com
•Beachsettings
•Spectacularvista
•Coastalhistory
ClubhouseatBaywood
32267ClubhouseWay LongNeck,DE19966
302.947.9225
BaywoodWeddings.com
•AwardWinningGardens&CeremonyGrounds
•OpenYear-RoundtothePublic
•StunningViews&CoastalCuisine
DelawareBotanicGardens
30220PineyNeckRoad, Dagsboro,DE19939 delawaregardens.org info@delawaregardens.org 302.321.9061
GrainontheRocks
43CapeHenlopenDr Lewes,DE19958
302.291.3900
GrainOnTheRocks.com
•Waterfrontrestaurantandbarwith outdoorseatingandlivemusic.
•LocatedattheCapeMay-Lewes FerryTerminal
• Tentedweddingreceptionson theDelawareBay,accommodating morethan300
GreaterGoodEventsby
Children’sBeachHouse
1800BayAvenue Lewes,DE
302.645.9184
GreaterGoodEventsDE.com
•On-andoff-sitecatering
•Bay-frontvenuewithindoor andbeachsideoptions
•Aportionofcostsbenefit Children’sBeachHouseprograms
TheGroveat HoltsLanding
27046HoltsLandingRoad Dagsboro,DE19939
302.227.6991
DeStateParks.com
•Anaturelover’sdream
•Bayside
•Firepit,pavillion,restrooms
HockersFamily
Restaurant&Crabhouse
30244CedarNeckRoad OceanView,DE19970
302.537.8900
hockersrestaurant@yahoo.com
FollowusonFBandInstagram!
•Privateroomforupto40
•Large,openvenuespace forupto350
•Customizedmenusby awardwinningchef

IndianRiver Life-SavingStation
25039CoastalHighway RehobothBeach,DE19971
302.227.6991
DeStateParks.com
•SoftbreezeofftheAtlantic, white,pristinesandybeaches
•Uniqueexperienceina relaxedsetting
•Indoordressingrooms andrestrooms
IndianRiverMarina
39415InletRoad RehobothBeach,DE19971 302.227.3071
DeStateParks.com
•Weddingceremonies
•GorgeousviewofIndianRiver andRehobothBays
•Cottagerentalsavailable
SussexCounty AssociationofRealtors 23407ParkAve. Georgetown,DE19947
302.855.2300
Scaor.com
•Versatilespaces
•Workingkitchens forcateredevents
•Maximumcapacity of125people
Tailchasers
12203CoastalHighway OceanCity,MD21842 443.664.7075
TailchasersOC.com
•Waterfrontdockbar
•Outdoordining
•Venuespacefor100-150

WheelhouseBar&Grill
7AnglersRd Lewes,DE19958
302.291.2163
WheelhouseDe.com
•WaterfrontDiningon theLewesCanal
•IndoororOutdoorDining
•Privatediningroom
•Weddings-EngagementsHolidayParties-FundraisersBaby/BridalShowersBusinessMeetingsRehearsalDinners
BanksWinesandSpirits 38014TownCenterDrive Millville,DE19967
302.537.8008
BanksWinesAndSpirits.com
•Extensivewineselection
•Beverageplanning
•Craftbeerkegs
•Largeselectionofsingle barrelbourbons
•Discountedpricingoncases ofwine&beer




